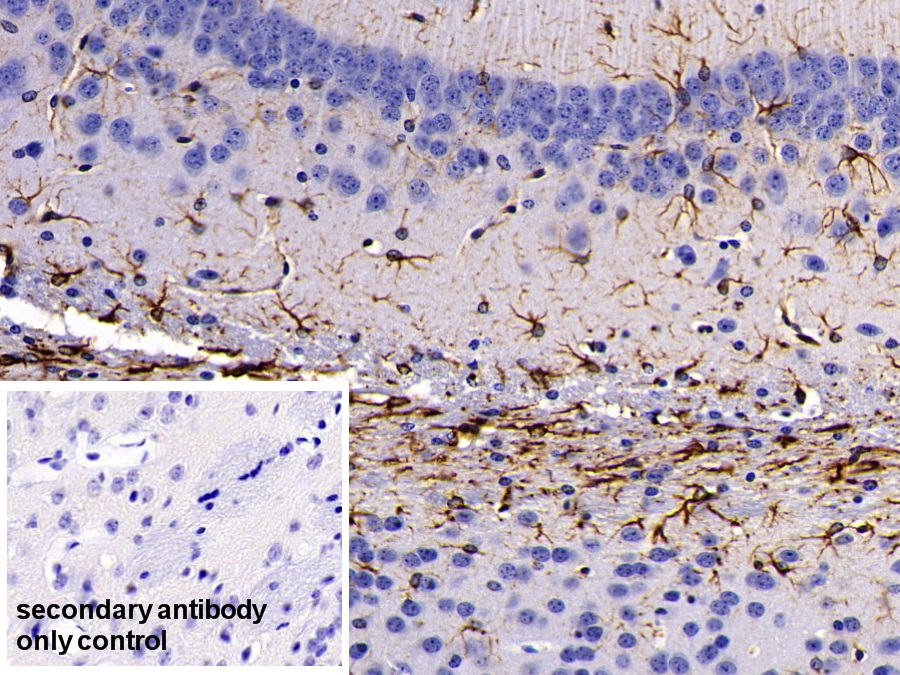

神经胶质纤维酸性蛋白(GFAP)多克隆抗体
Polyclonal Antibody to Glial Fibrillary Acidic Protein (GFAP)
Intermediate Filament Protein
- 编号PAA068Mu02
- 物种Mus musculus (Mouse,小鼠)相同的名称,不同的物种。
- 来源多抗制备
- 宿主兔
- 效价-
- Ig类型IgG
- 纯化方式抗原特异性亲和纯化
- 标记物无标记物
- 免疫原RPA068Mu02-神经胶质纤维酸性蛋白(GFAP)重组蛋白
- 缓冲液成份0.01M 磷酸盐缓冲液(pH7.4,containing 0.05% Proclin-300,50% glycerol)
- 性状液体
- 浓度0.5mg/mL
- 且适物种Rattus norvegicus (Rat,大鼠)
- 应用WB; IHC
如果抗体需用于流式细胞术,请参见流式抗体。 - 下载英文说明书 中文说明书
- 规格20µl100µl200µl1ml10ml
- 价格¥ 583¥ 1361¥ 1944¥ 4860¥ 19440
- 欲了解实际交易价格和更多情况,请与当地经销商联系!
特异性
该抗体是针对GFAP的兔多克隆抗体。在免疫组织化学染色和免疫印迹实验中能识别GFAP。
用法
Western blotting: 0.01-2µg/mL;
Immunohistochemistry: 5-20µg/mL;
Immunocytochemistry: 5-20µg/mL;
Optimal working dilutions must be determined by end user.
储存
经常使用则4°C保存。-20°C保存不超过两年。避免反复冻融。
稳定性
热稳定性以损失率显示。损失率是由加速降解试验决定,具体方法如下:在37°C孵育48小时,没有显著的降解或者沉淀产生。保质期内,在适当的条件下存储,损失率低于5%。
赠品
增值服务
相关产品
| 编号 | 适用物种:Mus musculus (Mouse,小鼠) | 应用(仅供研究使用,不用于临床诊断!) |
| RPA068Mu03 | 神经胶质纤维酸性蛋白(GFAP)重组蛋白 | Positive Control; Immunogen; SDS-PAGE; WB. |
| RPA068Mu02 | 神经胶质纤维酸性蛋白(GFAP)重组蛋白 | Positive Control; Immunogen; SDS-PAGE; WB. |
| RPA068Mu01 | 神经胶质纤维酸性蛋白(GFAP)重组蛋白 | Positive Control; Immunogen; SDS-PAGE; WB. |
| RPA068Mu04 | 神经胶质纤维酸性蛋白(GFAP)重组蛋白 | Positive Control; Immunogen; SDS-PAGE; WB. |
| PAA068Mu03 | 神经胶质纤维酸性蛋白(GFAP)多克隆抗体 | WB; IHC |
| PAA068Mu02 | 神经胶质纤维酸性蛋白(GFAP)多克隆抗体 | WB; IHC |
| PAA068Mu01 | 神经胶质纤维酸性蛋白(GFAP)多克隆抗体 | WB; IHC |
| PAA068Mu04 | 神经胶质纤维酸性蛋白(GFAP)多克隆抗体 | WB; IHC |
| MAA068Mu22 | 神经胶质纤维酸性蛋白(GFAP)单克隆抗体 | WB; IHC |
| MAA068Mu23 | 神经胶质纤维酸性蛋白(GFAP)单克隆抗体 | WB |
| MAA068Mu21 | 神经胶质纤维酸性蛋白(GFAP)单克隆抗体 | WB; IHC |
| MAA068Mu24 | 神经胶质纤维酸性蛋白(GFAP)单克隆抗体 | WB; IHC |
| MAA068Mu25 | 神经胶质纤维酸性蛋白(GFAP)单克隆抗体 | WB; IHC |
| MAA068Mu27 | 神经胶质纤维酸性蛋白(GFAP)单克隆抗体 | WB; IHC |
| MAA068Mu28 | 神经胶质纤维酸性蛋白(GFAP)单克隆抗体 | WB |
| MAA068Mu29 | 神经胶质纤维酸性蛋白(GFAP)单克隆抗体 | WB |
| SEA068Mu | 神经胶质纤维酸性蛋白(GFAP)检测试剂盒(酶联免疫吸附试验法) | Enzyme-linked immunosorbent assay for Antigen Detection. |
| MEA068Mu | 神经胶质纤维酸性蛋白(GFAP)检测试剂盒(酶联免疫吸附试验法,小样本) | Enzyme-linked immunosorbent assay for Antigen Detection. |
| LMA068Mu | 神经胶质纤维酸性蛋白(GFAP)等多因子检测试剂盒(流式荧光发光法) | FLIA Kit for Antigen Detection. |
| KSA068Mu01 | 神经胶质纤维酸性蛋白(GFAP)检测试剂盒DIY材料(酶联免疫吸附试验法) | Main materials for "Do It (ELISA Kit) Yourself". |
参考文献
| 杂志 | 参考文献 |
| Journal of Occupational Health | Effects of Exposure to 1-Bromopropane on Astrocytes and Oligodendrocytes in Rat Brain[Pubmed: 23183024] |
| Morfovirtual 2014 | EFECTO PROTECTOR DEL TRATAMIENTO CON NEUROEPO SOBRE LA GLIA DE LA CORTEZA CEREBRAL EN RATONES TRANSGéNICOS CON LA ENFERMEDAD DE ALZHEIMER.[Sld:Source] |
| Annals of Anatomy | Effect of memantine, a NMDA receptor blocker, on ethambutol-induced retinal injury[PubMed: 26704355] |
| Mediators of Inflammation | IL-4 Inhibits IL-1β-Induced Depressive-Like Behavior and Central Neurotransmitter Alterations[PubMed: 26417153] |
| Neurochem Res | Protective Effect of Oral Hesperetin Against Unilateral Striatal 6-Hydroxydopamine Damage in the Rat[PubMed: 26700436] |
| Cell Mol Neurobiol | Hypericum Perforatum Hydroalcoholic Extract Mitigates Motor Dysfunction and is Neuroprotective in Intrastriatal 6-Hydroxydopamine Rat Model of Parkinson’s Disease[PubMed: 26119304] |
| Sleep and Biological Rhythms | Relationship of orexin (hypocretin) system and astrocyte activation in Parkinson's disease with hypersomnolence[Doi: 10.1111] |
| Cellular and Molecular Neurobiology | Hypericum Perforatum Hydroalcoholic Extract Mitigates Motor Dysfunction and is Neuroprotective in Intrastriatal 6-Hydroxydopamine Rat Model of Parkinson’s Disease[Pubmed:26119304] |
| Ann Anat | Effect of memantine: A NMDA receptor blocker, on ethambutol-induced retinal injury[Pubmed:26704355] |
| United States Patent Application | ESTROGENIC COMPONENTS FOR USE IN THE TREATMENT OF NEUROLOGICAL DISORDERS[y2016:0101116.html] |
| Clinical Research | Human plasma glial fibrillary acidic protein and heat shock protein 27 concentrations in acute moderate-intensity aerobic exercise with different duration[a825e1e27b0221df9a627769c0f614432e92.pdf] |
| Medical Journal of Indonesia | Comparison of GFAP and HSP27 concentrations in acute moderate-intensity aerobic exercise of different duration[2031884] |
| Peptides. | Carnosine ameliorates cognitive deficits in streptozotocin-induced diabetic rats: Possible involved mechanisms.[pubmed:27777064] |
| european journal of pharmacology | Garlic active constituent s-allyl cysteine protects against lipopolysaccharide-induced cognitive deficits in the rat: Possible involved mechanisms.[pubmed:27915041] |
| european journal of pharmacology | Troxerutin exerts neuroprotection in 6-hydroxydopamine lesion rat model of Parkinson's disease: Possible involvement of PI3K/ERβ signaling.[pubmed:28284752] |
| biomedicine & pharmacotherapy | Acetyl-l-carnitine protects dopaminergic nigrostriatal pathway in 6-hydroxydopamine-induced model of Parkinson's disease in the rat.[pubmed:28199883] |
| J Endocrinol. | Estrogen receptors and estetrol-dependent neuroprotective actions: a pilot study.[pubmed:27799463] |
| IOS Press Content Library | An Intranasal Formulation of Erythropoietin (Neuro-EPO) Prevents Memory Deficits and Amyloid Toxicity in the APPSwe Transgenic Mouse Model of Alzheimer's …[articles:journal-of-alzheimers-disease] |
| Tierärztliche Hochschule Hannover | Evaluierung von Biomarkern im Liquor cerebrospinalis bei paraplegischen Hunden mit Rückenmarksverletzung[:] |
| Nigerian Journal of Clinical Practice | Utilization of Glial Fibrillary Acidic Protein and Galectin-3 in the Diagnosis of Cerebral Infarction Patients with Normal Cranial Tomography[pubmed:28406123] |
| Cytokine | Soy isoflavone genistein attenuates lipopolysaccharide-induced cognitive impairments in the rat via exerting anti-oxidative and anti-inflammatory effects[pubmed:29102164] |
| Biomedicine & pharmacotherapy | Berberine ameliorates intrahippocampal kainate-induced status epilepticus and consequent epileptogenic process in the rat: Underlying mechanisms[pubmed:28061403] |
| Experimental gerontology | The anti-aging protein klotho alleviates injury of nigrostriatal dopaminergic pathway in 6-hydroxydopamine rat model of Parkinson's disease: Involvement of PKA/CaMKII/CREB signaling.[pubmed:29107062] |
| Pesticide Biochemistry and Physiology | Acrolein-mediated neurotoxicity in growing Wistar male rats[Pubmed:30033014] |
| Journal of Perinatal Medicine | Mechanisms of death in structurally normal stillbirths[Pubmed: 30231013] |
| Metabolic Brain Disease | Berberine ameliorates lipopolysaccharide-induced learning and memory deficit in the rat: insights into underlying molecular mechanisms[Pubmed: 30456649] |
| Metabolic Brain Disease | Trigonelline protects hippocampus against intracerebral Aβ (1–40) as a model of Alzheimer's disease in the rat: insights into underlying mechanisms[Pubmed: 30421246] |
| 博士论文 | INSTITUTO DE CIENCIAS BÁSICAS Y PRECLÍNICAS “VICTORIA DE GIRÓN” DEPARTAMENTO DE HISTOLOGÍA[] |
| Medicina | The Administration of the New Pyrimidine Derivative—4-{2-[2-(3, 4-Dimethoxyphenyl)-Vinyl]-6-Ethyl-4-Oxo-5-Phenyl-4H-Pyrimidine-1-Il} Benzsulfamide Restores the …[] |
| Open Access Macedonian Journal of Medical Sciences | Inhibition of Receptor for Advanced Glycation End Products as New Promising Strategy Treatment in Diabetic Retinopathy[Pubmed: 32165929] |
| NEUROPSYCHOBIOLOGY | Diosgenin Attenuates Cognitive Impairment in Streptozotocin-Induced Diabetic Rats: Underlying Mechanisms[Pubmed: 32526752] |
| JAMA Surgery | Intraoperative dexmedetomidine for prevention of postoperative delirium in elderly patients with mild cognitive impairment[Pubmed: 28593326] |
| Acta Histochemica | Quercetin mitigates monosodium glutamate-induced excitotoxicity of the spinal cord motoneurons in aged rats via p38 MAPK inhibition[Pubmed: 32622428] |
| stanbul Med J | The Predictive Role of Neurobiochemical Markers in Multiple Sclerosis.[] |
| Basic and Clinical Neuroscience | Paeonol Protects Against Intrastriatal 6-Hydroxydopamine Rat Model of Parkinson's Disease[33995926] |
| pharmacology online | PHARMACOLOGICAL SCREENING OF A POTENTIALLY EFFECTIVE COMPOUND FOR THE TREATMENT OF CHRONIC TRAUMATIC ENCEPHALOPATHY?¡[] |
| Neuropeptides | The bee venom active compound melittin protects against bicuculline-induced seizures and hippocampal astrocyte activation in rats[34808488] |
| Neural Plast | P2Y2 Receptor Mediated Neuronal Regeneration and Angiogenesis to Affect Functional Recovery in Rats with Spinal Cord Injury[Pubmed:35154311] |